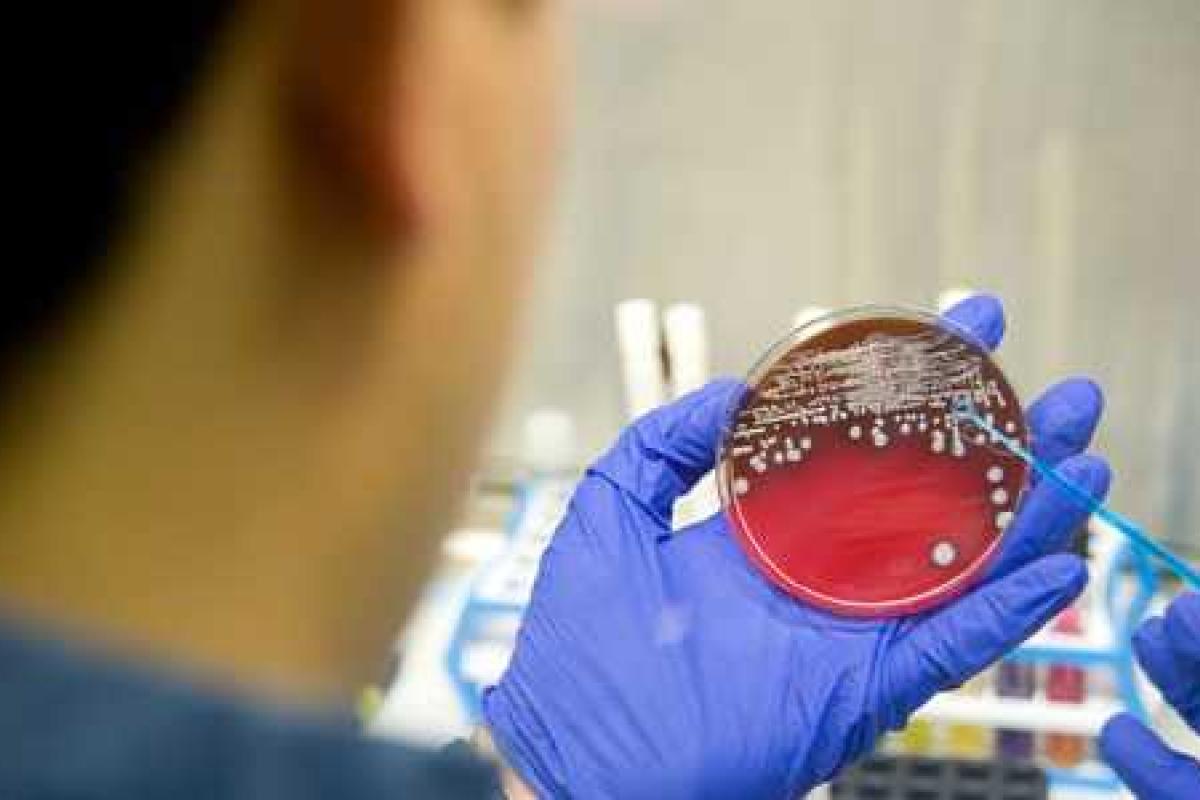

Десятки граждан подхватили смертельный вирус в Запорожской, Львовской и Киевской областях. Более двадцати детей были срочно госпитализированы. По словам врачей, заболевание может распространяться очень быстро, и каждому украинцу нужно внимательно следить за своим здоровьем и за самочувствием близких. Менингит «запускать» нельзя – болезнь быстро поражает все органы и приводит к смертельному исходу, если вовремя не оказать медицинскую помощь.
Настоящая эпидемия наблюдается во Львове, где за несколько дней обнаружили 23 пациента с менингитом. Заболевание чаще всего встречается среди детей, поэтому родители должны при первых симптомах болезни сразу обращаться в больницу.
Многие жители Львова сейчас запрещают детям посещать школы и детские сады. Однако, по словам педагогов и воспитателей, в дошкольных и образовательных учреждениях тщательно следят за санитарно-гигиеническими нормами, и риск заразиться менингитом – минимальный.
Медики просят всех соблюдать спокойствие и даже отмечают, что пока рано говорить о массовой эпидемии. По их словам, вспышка менингита – сезонная, поскольку заболевание всегда развивается на фоне резких изменений в погоде.
Организм человека, привыкший к комфортной температуры, тяжело переносит сырость, похолодание и отсутствие солнца. С начала 2015 года в нашей стране менингитом заболело 47 человек, и эта цифра несколько выше, чем в 2014 году, однако причины для паники пока отсутствуют.
















